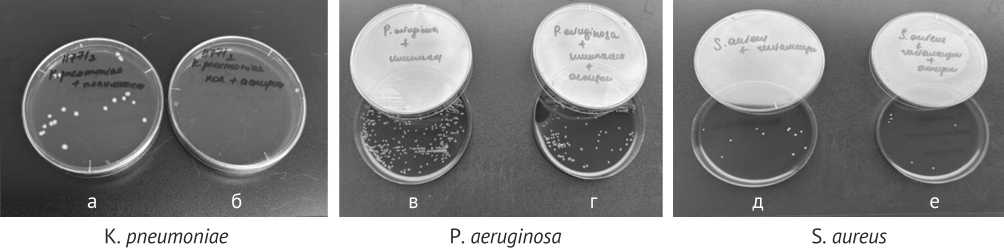
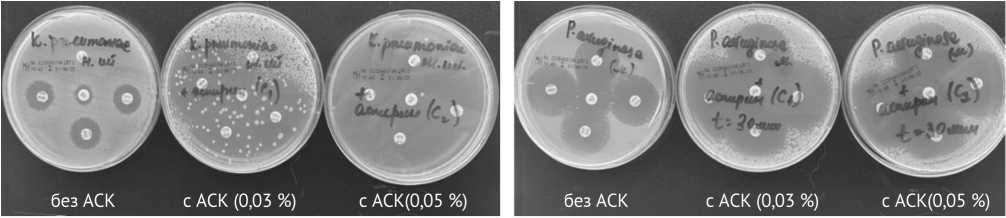

Перспективы применения ацетилсалициловой кислоты в комбинации с антибактериальными препаратами против ведущих возбудителей остеомиелита
Автор: Шипицына И.В., Осипова Е.В., Шастов А.Л.
Журнал: Гений ортопедии @geniy-ortopedii
Рубрика: Оригинальные статьи
Статья в выпуске: 1 т.32, 2026 года.
Бесплатный доступ
Актуальность. Ацетилсалициловая кислота (АСК) — один из перспективных кандидатов для усиления действия антибактериальных препаратов. Цель работы — оценить in vitro влияние аспирина в комбинации с антибактериальными препаратами на рост микробных культур клинически значимых штаммов бактерий при остеомиелите. Материалы и методы. Объект исследования — клинически значимые штаммы бактерий K. pneumoniae (n = 12), P. aeruginosa (n = 12), S. aureus (n = 12), S. epidermidis (n = 12), выделенные из ран пациентов c хроническим остеомиелитом. Эксперимент разделен на четыре серии: контрольная группа, группы с АСК, антибиотиком, АСК и антибиотиком. Антибактериальное действие оценивали по отсутствию зоны роста бактерий вокруг дисков. Результаты. При совместной инкубации ACK (0,05 %) с грамотрицательными бактериями (K. pneumoniae, P. aeruginosa) на чашках Петри отсутствовал рост микроорганизмов. В случае с бактериями S. aureus количество КОЕ было снижено по сравнению с контрольной группой. На чашках с S. epidermidis отсутствовал рост. При совместной инкубации полимиксина с P. aeruginosa на чашках Петри регистрировали незначительный рост бактерий, в случае с K. pneumoniae наблюдали лишь отдельные колонии. При инкубации совместно с полимиксином и аспирином (0,03 %) на чашках с K. pneumoniae роста микроорганизмов не было, на чашках с P. aeruginosa отмечали незначительный рост. Гентамицин подавлял рост бактерий S. aureus (на чашках отмечали незначительное количество бактерий). АСК (0,03 %) усиливал бактерицидные свойства гентамицина (на чашках отсутствовал рост бактерий). Обсуждение. Отсутствие под действием АСК роста на чашках c бактериями S. epidermidis, даже без антибиотиков, позволяет предположить, что одним из механизмов действия может быть подавление адгезии и формирование биоплёнки. Наличие выраженного эффекта АСК в отношении грамотрицательных бактерий (K. pneumoniae, P. aeruginosa) может быть связано с воздействием на наружную мембрану микробных клеток, в то время как на грамположительные бактерии (S. aureus), аспирин оказывал меньшее влияние, лишь снижая метаболическую активность. Заключение. Наше исследование продемонстрировало, что ацетилсалициловая кислота in vitro проявляет синергизм с рядом антибиотиков, значительно усиливая их бактерицидную активность в отношении клинических изолятов, ассоциированных с остеомиелитом.
Ацетилсалициловая кислота, хронический остеомиелит, S. aureus, S. epidermidis, K. pneumoniae, P. aeruginosa
Короткий адрес: https://sciup.org/142247047
IDR: 142247047 | УДК: 616.71-018.46-002:(615.276+615.281):615.036 | DOI: 10.18019/1028-4427-2026-32-1-31-37
Prospects for using acetylsalicylic acid in combination with antibacterial drugs against the leading pathogens of osteomyelitis
Introduction Acetylsalicylic acid (ASA) is one of the promising candidates for enhancing the action of antibacterial drugs. Purpose To evaluate in vitro the effect of aspirin in combination with antibacterial drugs on the growth of microbial cultures of clinically significant bacterial strains in osteomyelitis. Materials and methods The object of the study is clinically significant bacterial strains K. pneumoniae (n = 12), P. aeruginosa (n = 12), S. aureus (n = 12), S. epidermidis (n = 12), isolated from wounds of patients with chronic osteomyelitis. The experiment was divided into four series: control group; group of ASA administration; group of antibiotic administration; group of ASA + antibiotic administration. Antibacterial effect was assessed by the absence of a bacterial growth zone around the discs. Results There was no growth of microorganisms on Petri dishes when ASA (0.05 %) was incubated with gram-negative bacteria (K. pneumoniae, P. aeruginosa). In the case of S. aureus bacteria, the number of CFU was reduced compared to the control group. There was no growth on plates with S. epidermidis. When polymyxin was incubated with P. aeruginosa, slight bacterial growth was recorded on Petri dishes, while only individual colonies were observed with K. pneumoniae. When incubated together with polymyxin and aspirin (0.03 %), there was no growth of microorganisms on plates with K. pneumoniae, while slight growth was noted on plates with P. aeruginosa. Gentamicin suppressed the growth of S. aureus bacteria (an insignificant number of bacteria was noted on the plates). ASA (0.03 %) enhanced the bactericidal properties of gentamicin (there was no bacterial growth on the plates). Discussion The absence of growth on plates with S. epidermidis bacteria under the influence of ASA, even without antibiotics, suggests that one of the mechanisms of its action may be the suppression of adhesion and biofilm formation. The presence of a pronounced effect of ASA on gram-negative bacteria (K. pneumoniae, P. aeruginosa) may be associated with the effect on the outer membrane of microbial cells, while aspirin had a lesser effect on gram-positive bacteria (S. aureus) and only reduced metabolic activity. Conclusion Our study demonstrated that acetylsalicylic acid exhibits synergism with a number of antibiotics in vitro and significantly enhances their bactericidal activity against clinical isolates associated with osteomyelitis.
Текст научной статьи Перспективы применения ацетилсалициловой кислоты в комбинации с антибактериальными препаратами против ведущих возбудителей остеомиелита
Остеомиелит — тяжелое инфекционно-воспалительное заболевание костной ткани, вызываемое преимущественно бактериальными возбудителями, такими как Staphylococcus aureus , Pseudomonas aeruginosa , и другими патогенами [1–4]. Несмотря на достижения современной антимикробной терапии, лечение пациентов с остеомиелитом остается сложной задачей из-за формирования биоплёнок, устойчивости к антибиотикам и хронизации воспалительного процесса [5–7]. В связи с этим, актуальным направлением является поиск новых стратегий терапии, включающих комбинацию антибактериальных препаратов с адъювантными средствами, способными усиливать их эффективность.
Ацетилсалициловая кислота (АСК) — один из перспективных кандидатов для усиления действия антибактериальных препаратов. Помимо известного противовоспалительного и антиагрегантного действия, аспирин демонстрирует способность модулировать активность антибиотиков, подавлять образование бактериальных биопленок и влиять на иммунный ответ [8–11]. В последние годы появляются данные о его синергизме с некоторыми антибактериальными препаратами в отношении устойчивых штаммов микроорганизмов [12].
Цель работы — оценить in vitro влияние аспирина в комбинации с антибактериальными препаратами на рост микробных культур клинически значимых штаммов бактерий при остеомиелите.
МАТЕРИАЛЫ И МЕТОДЫ
Объект исследования — клинически значимые штаммы бактерий K. pneumoniae ( n = 12), P. aeruginosa ( n = 12), S. aureus ( n = 12), S. epidermidis ( n = 12), выделенные из ран пациентов c хроническим остеомиелитом.
Исследование биоматериалов, полученных от пациентов, выполняли в соответствии с принятыми международными стандартами (UK SMI). Видовую идентификацию микробных культур проводили методом MALDI-TOF масс-спектрометрии. Чувствительность бактерий к антимикробным препаратам (K. pneumoniae — к ципрофлоксацину, цефепиму, имипенему, меропенему; P. aeruginosa — к ципрофлоксацину, цефепиму, имипенему, меропенему, амикацину, пиперациллин/тазобактаму; S. aureus и S. epidermidis — к ванкомицину, гентамицину, ципрофлоксацину, эритромицину, цефокситину), включенным в формулярный перечень Центра, определяли согласно критериям EUCAST ( англ .: European Committee on Antimicrobial Susceptibility Testing, Version 9.0, valid from 2019-01-01).
Критерий включения: клинические штаммы в пределах одной таксономической группы, характеризовавшиеся сходной чувствительностью к тестируемым антибактериальным препаратам. В эксперимент вошли только метициллин-чувствительные штаммы стафилококков.
В качестве тест-культур использовали музейные штаммы бактерий, принадлежащих к четырем таксономическим группам: Pseudomonas aeruginosa АТСС 27853, Klebsiella pneumoniae АТСС 700603, Staphylococcus aureus АТСС 29213, Staphylococcus epidermidis АТСС 14990.
Эксперимент разделен на четыре серии:
-
— контрольная серия — готовили суспензии исследуемых культур, содержащие 5×106 КОЕ/мл (колониеобразующие единицы) бактерий;
-
— вторая серия (0,03 % АСК, 300 мкг/мл) — во второй части эксперимента по 1 мл АСК вносили в пробирки с культурами, содержащими 5×106 КОЕ/мл бактерий, инкубировали при комнатной температуре в течение 30 мин;
-
— третья серия — полимиксин (5 мг/мл) в случае с грамотрицательными бактериями и гентамицин (40 мг/мл) в случае с грамположительными бактериями инкубировали при комнатной температуре в течение 30 мин совместно с суспензиями, содержащими 5×106 КОЕ/мл микробных клеток;
-
— четвертая серия — суспензии бактерий (5×106 КОЕ/мл) инкубировали с комбинацией АСК (0,05 %) с антибиотиками (полимиксином или гентамицином) в течение 30 мин.
Полимиксин обладает активностью против устойчивых грамотрицательных бактерий (P. aeruginosa , A. baumannii , K. pneumoniae , E. coli ), является препаратом выбора для лечения инфекций, вызванных бактериями с резистентностью к карбапенемам. Полимиксины действуют путем разрушения внешней мембраны грамотрицательных бактерий (выступая в роли детергента). Гентамицин обладает высокой бактерицидной активностью в отношении стафилококков.
Для получения газона микробные взвеси в каждой серии эксперимента с помощью ватного тампона наносили на поверхность агара Мюллера – Хинтон, на поверхность которого помещали диски с ан- тибиотиками и инкубировали в течение суток в термостате при 37°. Одновременно делали высевы на агар Шедлера с бараньей кровью (с гемином и витамином К1) для учета роста микробных клеток. Результаты оценивали через сутки.
Антибактериальное действие оценивали по отсутствию зоны роста бактерий вокруг дисков.
Все эксперименты проводили в трёх повторах, данные представлены в виде среднего арифметического значения (М) и стандартного отклонения (SD). Статистические тесты выполнены в программе Gnumeric 1.12.17. Cравнение групп проводили с помощью критерия Стьюдента после предварительного определения типа распределения в выборках с помощью критерия Андерсона – Дарлинга. Порог значимости для всех тестов составлял р < 0,05.
Работа выполнена в формате in vitro исследования без участия животных или человека.
РЕЗУЛЬТАТЫ
При совместной инкубации АСК (0,05 %) с грамотрицательными бактериями (K. pneumoniae , P. aeruginosa ) на чашках Петри отсутствовал рост микроорганизмов. В случае с бактериями S. aureus количество КОЕ было снижено в сравнении с контрольной группой. На чашках с S. epidermidis рост отсутствовал (рис. 1).

Грамотрицательные бактерии (Р. aeruginosa, К. pneumoniae')
Грамположительные бактерии (S. aureus, S. epidermidis)
Рис. 1. Влияние АСК на рост бактерий P. aeruginosa , K. pneumoniae , S. aureus , S. epidermidis . На чашках справа — контрольная серия, слева — с АСК
При совместной инкубации полимиксина с P. aeruginosa на чашках Петри регистрировали незначительный рост бактерий, в случае с K. pneumoniae наблюдали лишь отдельные колонии. При инкубации совместно с полимиксином и АСК (0,03 %) на чашках с K. pneumoniae роста микроорганизмов не было, на чашках с P. aeruginosa отмечали незначительный рост. Гентамицин подавлял рост бактерий S. aureus (на чашках отмечали незначительное количество бактерий). АСК (0,03 %) усиливал бактерицидные свойства гентамицина (на чашках отсутствовал рост бактерий) (рис. 2).
Рис. 2. Влияние АСК на рост микробных культур K. pneumoniae , P. aeruginosa , S. aureus на кровяном агаре после инкубации с антибиотиком и комбинации антибиотика с АСК: а, в — полимиксин (5 мг/мл); б, г — полимиксин (5 мг/мл) + АСК (0,03 %); д — гентамицин (40 мг/мл); е — гентамицин (40 мг/мл) + АСК (0,03 %)
Также наблюдали различия в зонах задержки роста бактерий при постановке антибиотикочувстви-тельности в зависимости от концентрации АСК (рис. 3, б, в). Для штаммов K. pneumomiae при использовании АСК (0,03 %) зоны задержки роста бактерий не отличались от контрольной группы, однако число жизнеспособных клеток на поверхности агара было ниже (рис. 3, д).
a - музейный штамм К. pneumoniae
б - музейный штамм Р. aeruginosa

В группе с АСК значимые различия в зонах задержки роста наблюдали для клиндамицина и цефок-ситина в сравнении с контрольной серией для клинических штаммов S. aureus (табл. 1). Для штаммов S. epidermidis отмечены отличия в зоне задержки роста бактерий для клиндамицина (табл. 2). На чашках с P. aeruginosa значимые изменения в зонах задержки роста наблюдали для имипенема, меропенема, цефепима и ципрфлоксацина (табл. 3).
Таблица 1
Таблица 2
Диаметр зоны задержки роста бактерий S. aureus Диаметр зоны задержки роста бактерий S. epidermidis
|
Препарат (мкг) |
Диаметр зоны задержки роста бактерий S. aureus , мм |
|
|
контрольная серия, n = 12 |
АСК (0,05 %), n = 12 |
|
|
Клиндамицин (2) |
25 ± 2 |
32 ± 2* |
|
Цефокситин (30) |
29 ± 3 |
33 ± 2* |
|
Ванкомицин (5) |
19 ± 1 |
19 ± 1 |
|
Гентамицин (30) |
23 ± 2 |
24 ± 2 |
|
Ципрофлоксацин (5) |
25 ± 3 |
25 ± 2 |
|
Эритромицин (15) |
26 ± 2 |
28 ± 3 |
|
Препарат (мкг) |
Диаметр зоны задержки роста бактерий S. epidermidis , мм |
|
|
контрольная серия, n = 12 |
АСК(0,05 %), n = 12 |
|
|
Клиндамицин (2) |
24 ± 2 |
29 ± 2* |
|
Цефокситин (30) |
25 ± 2 |
26 ± 2 |
|
Ванкомицин (5) |
19 ± 1 |
19 ± 1 |
|
Гентамицин (30) |
25 ± 3 |
24 ± 2 |
|
Ципрофлоксацин (5) |
26 ± 2 |
25 ± 2 |
|
Эритромицин (15) |
25 ± 2 |
27 ± 2 |
Примечание : n — число штаммов, * — уровень значимости различий между контрольной серией и опытной с АСК, p < 0,05.
Таблица 3
Зона задержки роста бактерий P. aeruginosa
|
Антибактериальный препарат (мкг) |
Зона задержки роста бактерий P. aeruginosa , мм |
|
|
контрольная серия, n = 12 |
АСК (0,05 %), n = 12 |
|
|
Имипенем (10) |
24 ± 3 |
30 ± 2* |
|
Меропенем (10) |
29 ± 2 |
33 ± 1* |
|
Цефепим (30) |
28 ± 3 |
32 ± 2* |
|
Пиперациллин/тазобактам (30/6) |
26 ± 2 |
26 ± 3 |
|
Амикацин (30) |
22 ± 2 |
25 ± 2 |
|
Ципрофлоксацин (5) |
28 ± 2 |
33 ± 2* |
Примечание : n — число штаммов, * — уровень значимости различий между контрольной серией и опытной с АСК, p < 0,05.
ОБСУЖДЕНИЕ
Нестероидные противовоспалительные средства (НПВС) традиционно применяют в качестве противовоспалительных, болеутоляющих и жаропонижающих препаратов. Вместе с тем, имеются данные о воздействия НПВС на бактерии и связанные с ними инфекции [13]. Данные об активности НПВП in vitro против планктонных бактерий и биоплёнок на сегодняшний день противоречивы [14–17].
Один из представителей НПВС — ацетилсалициловая кислота, являющаяся синтетическим производным салициловой кислоты. Действие АСК — комплексное, зависит от дозировки. Противовоспалительное, жаропонижающее и обезболивающее (используются средние/высокие дозы ~ 500–1000 мг) действия реализуются через ингибирование ферментов циклооксигеназ (ЦОГ-1 и ЦОГ-2), которые участвуют в синтезе простагландинов, — веществ, вызывающих боль и отек при воспалении; антиагрегантное (используются низкие дозы ~ 75–100 мг.) действие реализуется через блокаду ЦОГ-1 в тромбоцитах.
В разных исследованиях приведены данные о влиянии АСК на тромбоциты после воздействия бактериями (Staphylococcus aureus , Enterococcus faecalis , Streptococcus pyogenes , Escherichia coli ) [18, 19]. Показано, что клинические штаммы S. aureus могут вызывать активацию тромбоцитов, экспрессию маркеров клеточной гибели и высвобождение факторов воспаления [18, 19]. Ацетилсалициловая кислота ограничивает воздействие S. aureus на тромбоциты, снижая темпы гибели клеток, восстанавливает их количество и уменьшая вклад тромбоцитов в воспаление, связанное с присутствием в крови бактериальных патогенов.
В настоящее время изучают способность аспирина оказывать влияние на образование биопленок микроорганизмами; проявлять синергизм с антибиотиками, повышая проницаемость клеточных стенок бактерий и делая их более уязвимыми; модулировать иммунный ответ организма [8–12]. L.I. Kupferwasser et al. сделали вывод об усилении чувствительности MRSA к ß-лактамным антибиотикам в присутствии аспирина [9]. В другой работе показано усиление активности ванкомицина против устойчивых энтерококков в присутствии аспирина [20]. В ряде исследований приводятся данные о бактериостатическом действии АСК на грамположительные бактерии и отсутствие эффекта при воздействии на грамотрицательные бактерии [13]. S.A. El-Mowafy et al. при исследовании QS-ингибирующее действия АСК на P. aeruginosa наблюдали снижение подвижности бактерий [21]. В другом исследовании показали, что воздействие АСК в течение 1,5 часов приводило к удалению 30 % биоплёнок, образованных S. Epidermidis и P. aeruginosa на полистироле [22].
В литературе имеются данные, свидетельствующие о формировании устойчивых популяций бактерий после воздействия НПВП, в том числе и АСК [14, 23].
В нашем исследовании отсутствие роста на чашке c бактериями S. epidermidis в присутствии АСК, даже без антибиотиков, позволяет предположить, что одним из механизмов действия может быть подавление адгезии и формирования биоплёнки [24]. Наличие выраженного эффекта АСК в отношении грамотрицательных бактерий (K. pneumoniae , P. aeruginosa ) может быть связано с его воздействием на наружную мембрану микробных клеток, в то время как на грамположительные бактерии (S. aureus ) препарат оказывал меньшее влияние, лишь снижая метаболическую активность. Аспирин, будучи слабой кислотой, также может нарушать целостность мембран и повышать их проницаемость [8].
Наши результаты позволяют предположить, что АСК усиливает действие полимиксина. Усиление бактерицидного действия гентамицина в присутствии АСК на S. aureus может быть связано со способностью салицилатов подавлять синтез белка и нарушать энергетический метаболизм бактерий, что повышает эффективность накопления аминогликозидов внутри клетки [13].
Данное исследование носит больше описательный характер. В перспективе планируется определение индексов МИК (минимальная ингибирующая концентрация) и FIC (фракционная ингибирующая концентрация) для подтверждения синергизма, изучение влияния АСК на зрелые биоплёнки и оценка эффективности комбинации на соответствующих in vivo моделях остеомиелита.
ЗАКЛЮЧЕНИЕ
Исследование продемонстрировало, что ацетилсалициловая кислота in vitro проявляет синергизм с рядом антибиотиков, значительно усиливая их бактерицидную активность в отношении клинических изолятов, ассоциированных с остеомиелитом.


